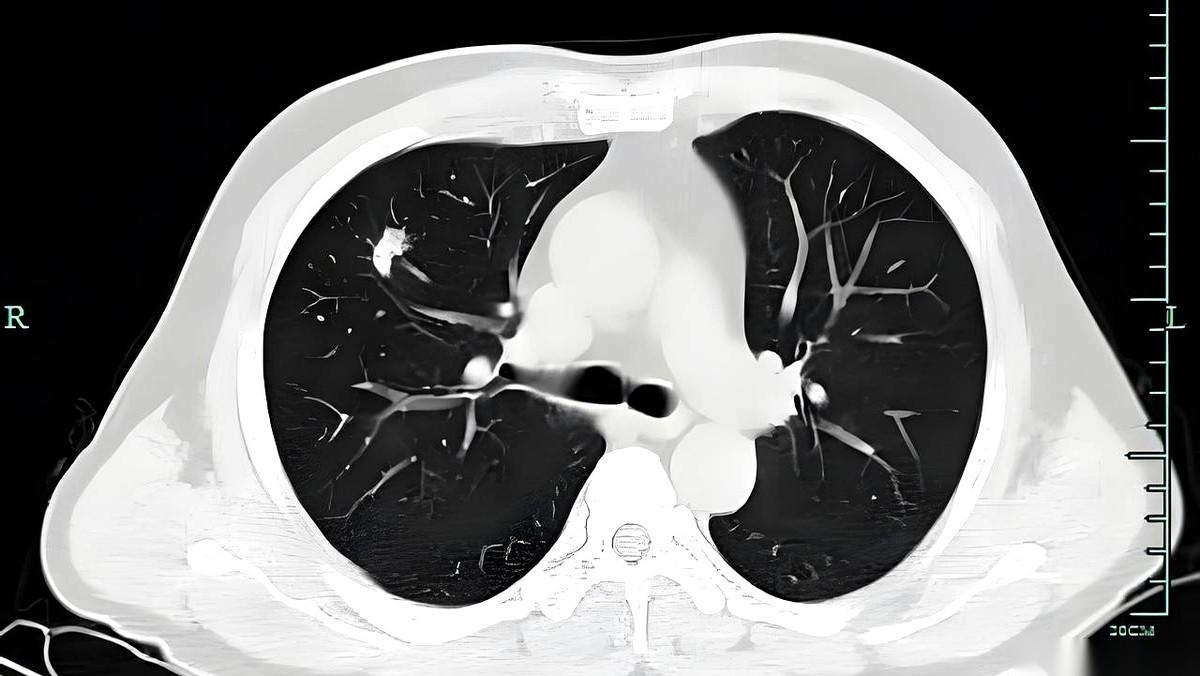
CT报告一出来，魂儿先没了一半。磨玻璃结节、索条影、钙化灶……一堆看不懂的名

㊗高蛋白食物:如螃蟹、虾、牛奶等。柿子含大量鞣酸,蛋白质在鞣酸的作用下易凝结成块,形成胃柿石。大量进食后,胃柿石难以消化且不易排出,可能造成消化道梗阻,出现腹痛、呕吐等症状。 ㊗ 酸性食物:像山楂、橘子等。这类食物会使胃酸分泌增加,与柿子中的鞣酸、果胶相遇,更易形成胃柿石,增加肠胃负担。 ㊗ 红薯:红薯在胃中会产生大量胃酸,柿子遇胃酸后易形成沉淀,积聚过多可能形成结石,危害肠胃健康。 ㊗食用柿子时,应避免与上述食物搭配。若食用后出现腹痛、腹胀、呕吐等不适症状,要及时就医。另外,柿子不宜空腹吃,且一次食用量不宜过多,一般不超过2个。